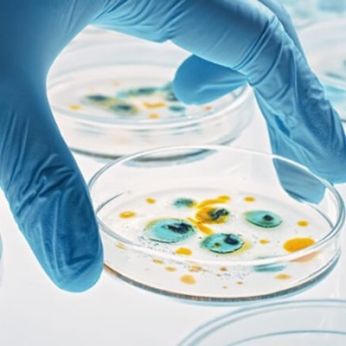

Wheeler Bio
Silver Sponsor
Information
Wheeler Bio is a biomanufacturing pioneer founded by a team of industry experts and strategic investors who believe a different CDMO model is needed for innovators to bring new therapeutic leads to the clinic faster, without the risk and cost associated with traditional outsourcing models. Our novel hub-and-spoke concept, centered in Oklahoma City with satellite labs embedded in discovery centers on the coasts, will revolutionize the translational path from discovery to CMC development and first patient dosing. Wheeler’s pioneering, highly-accessible, open-source development platform – Portable CMC® – delivers speed to clinic and uniquely-affordable workflows by integrating discovery CROs and CDMOs. Portable CMC® is a suite-ready drug substance manufacturing platform that customers can transfer to any CDMO in the world with no royalties, licensing fees or penalties. By overlapping with the discovery workflow, Portable CMC® reduces timelines and regulatory risks through the introduction of QbD (Quality-by-Design) principles earlier on in the drug development life cycle, increasing the opportunity for clinical success.